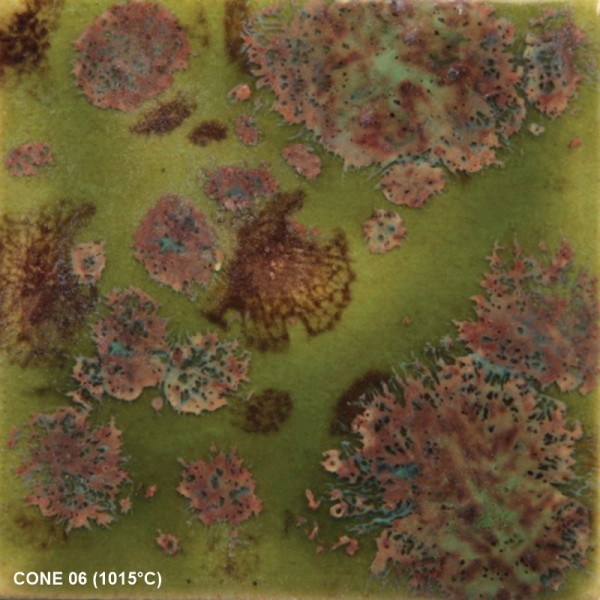
Mayco Jungle Gems CG716, Pagoda Green

inkl. MwSt. zzgl. Versandkosten
Lieferzeit je nach Verfügbarkeit 2-10 Tage
- Artikel-Nr.: CG-716
- EAN: 097539334645
Mayco Jungle Gems Crystal Glaze CG-916, Pagoda Green
Flüssigglasur im 118-ml-Gebinde
Verleihen Sie Ihren Keramikprojekten eine einzigartige und faszinierende Optik mit der Jungle Gems Crystal Glaze CG-916, Pagoda Green von Mayco. Diese hochwertige Flüssigglasur zaubert eine lebendige Oberfläche voller dynamischer Effekte und farbenfroher Kristalle. Die CG-916, Pagoda-Green-Glasur ist ideal für dekorative Keramiken, Vasen, Schalen und andere kreative Projekte. Durch die vielseitigen Effekte können Sie Ihre Designs individuell gestalten und mit einem professionellen Finish versehen. Pagoda Green ist eine transparente grüne Grundglasur mit variierenden salbeigrünen und braunen Kristallen.
Anwendung: Vor jeder Anwendung gut schütteln und umrühren, um die Kristalle in der Glasur zu verteilen. Verwenden Sie einen Fächerpinsel und tragen Sie 2-3 gleichmäßige Schichten auf geschrühte Keramik (Cone 04, 1060 °C) auf. Zwischen den Schichten trocknen lassen. Während des Auftragens der dritten Schicht müssen die Kristalle möglicherweise neu verteilt werden, um eine gleichmäßige Abdeckung zu gewährleisten. Vermeiden Sie es, Kristalle in die Nähe des Bodens des Werkstücks zu platzieren, da die Kristalle aufgrund ihrer Fließeigenschaften verlaufen können. Gut trocknen lassen. Brennen Sie die Glasur bei Cone 06/05 (999 °C – 1046 °C). Besuchen Sie MaycoColors.com für vollständige Sicherheitsdaten (SDS) und weitere Produktinformationen.
Nicht sprühauftragbar. Nicht für Geschirr empfohlen; nur für dekorative Zwecke.
WARNUNG: Kann schädlich sein, wenn es verschluckt wird. Enthält Kupfer. Vorsichtsmaßnahmen: Verschlucken vermeiden. Hände sofort nach Gebrauch waschen. Während der Anwendung nicht essen, trinken oder rauchen. VON KINDERN FERNHALTEN. ERSTE-HILFE-MAßNAHME: Bei Verschlucken unverzüglich ärztliche Hilfe aufsuchen.

| Produktgruppen Glasuren: | Irdenware 1020° - 1100°C |
| Deckkraft Glasur: | transparent |
| Farbton Glasur: | Bunt |
| Gebindegröße Glasur: | 118 ml / 4 fl oz |